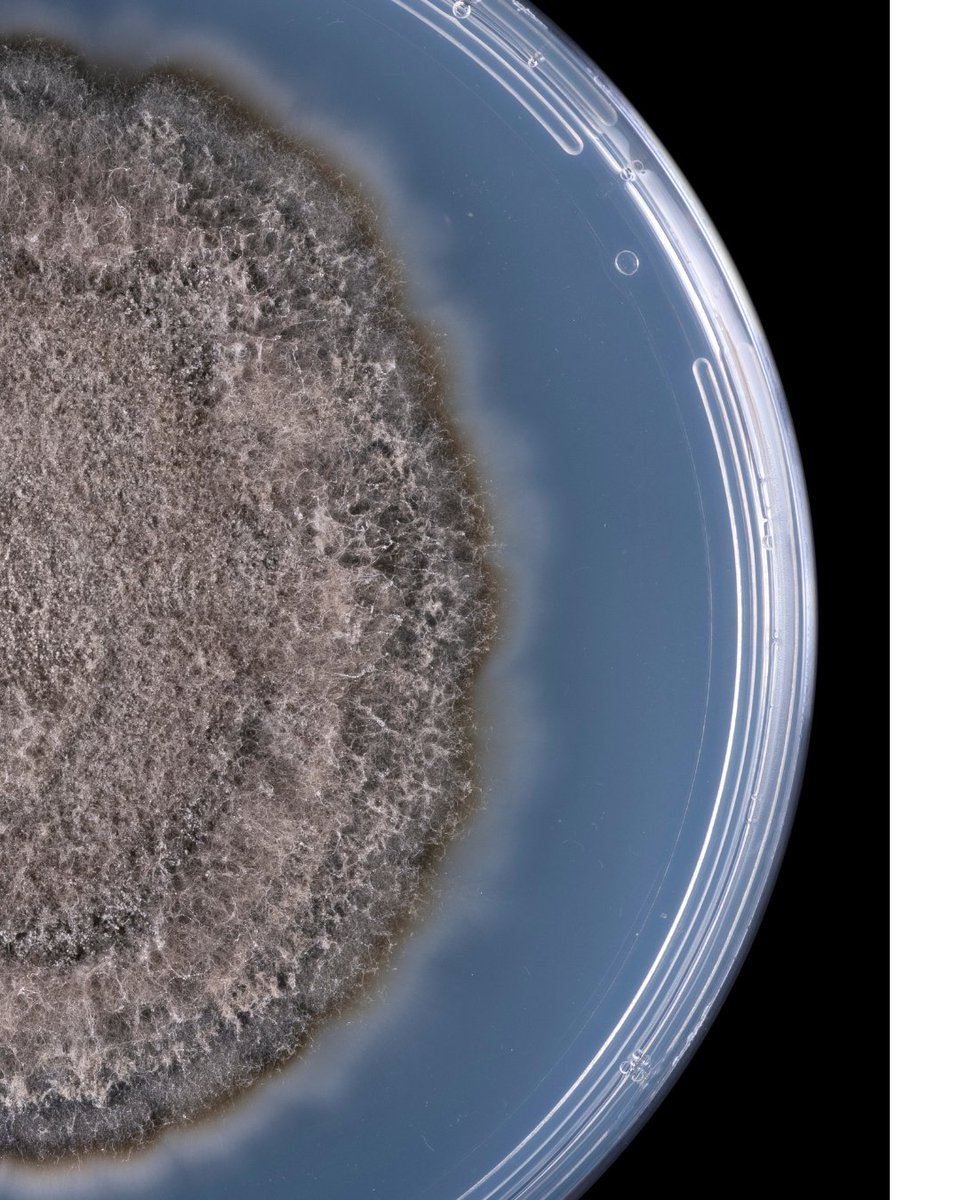
Ever wondered if our products are genetically modified? Spoiler—they're not! Swipe to find out why. 🌿✨

Loam Bio AU
@loambio
Loam works with farmers and scientists to enable high quality carbon sequestration, driven by our novel CarbonBuilder technology.
ID: 1237985744460767232
https://www.loambio.com/au/blog/2024/05/30/australian-researchers-lead-soil-science-breakthrough/ 12-03-2020 06:16:30
641 Tweet
1,1K Takipçi
543 Takip Edilen